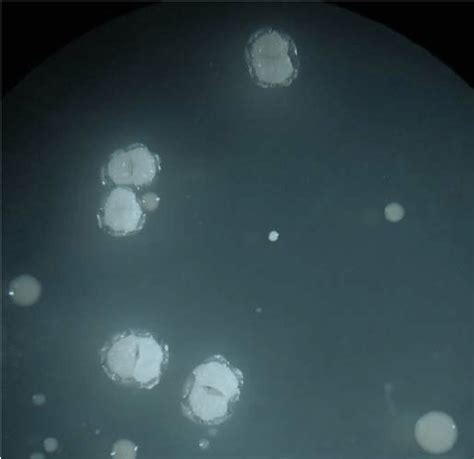

TYCSB Agar: Your Ultimate Guide
TYCSB Agar: Your Ultimate Guide
Hey there, fellow lab enthusiasts and science wizards! Today, we’re diving deep into the fascinating world of TYCSB Agar , a superstar medium that’s probably been helping you out in the lab without you even realizing its full potential. You know, sometimes we use these amazing tools day in and day out, and it’s not until we really stop and think about why they’re so awesome that we truly appreciate them. Well, consider this your official deep dive into TYCSB Agar. We’ll break down what it is, why it’s a must-have in your microbial arsenal, and some cool tips and tricks to get the most out of it. So, grab your lab coat, maybe a cup of coffee, and let’s get nerdy!
Table of Contents
- What Exactly is TYCSB Agar, Anyway?
- Why is TYCSB Agar So Popular?
- The Science Behind the Success: Key Components of TYCSB Agar
- Tryptone: The Protein Powerhouse
- Yeast Extract: The Vitamin and Growth Factor Bonanza
- Casein Soya Peptone: The Broad-Spectrum Support
- Agar: The Solid Foundation
- Applications: Where Does TYCSB Agar Shine?
- General Purpose Cultivation and Isolation
- Quality Control in Various Industries
- Stock Cultures and Maintenance
- Educational Purposes
- Tips for Using TYCSB Agar Like a Pro
- Proper Preparation is Key
- Storage Matters
- Know Your Organisms
- Incubation Conditions
- Conclusion: TYCSB Agar - A Reliable Workhorse
What Exactly is TYCSB Agar, Anyway?
Alright, let’s start with the basics, guys. TYCSB Agar is essentially a Tryptone Yeast Extract Casein Soya Broth Agar . See those initial letters? They spell out TYCSB! Pretty neat, right? This formulation is designed to be a general-purpose nutrient medium, which means it’s pretty darn versatile. It provides all the essential nutrients that a wide range of microorganisms need to grow and thrive. Think of it as a gourmet meal for your microbes – a balanced diet of proteins, carbohydrates, vitamins, and minerals. The tryptone and yeast extract provide a rich source of amino acids, peptides, and B vitamins, which are crucial for microbial metabolism and growth. Casein soya, on the other hand, offers a broader spectrum of nutrients, including complex proteins and carbohydrates, further supporting the growth of diverse microbial species. This combination makes TYCSB Agar a go-to choice for many microbiological applications, from routine quality control to more specialized research.
Why is TYCSB Agar So Popular?
So, why has TYCSB Agar become such a staple in labs around the globe? Well, its popularity stems from its versatility and reliability . Unlike some highly specialized media that cater to very specific organisms, TYCSB Agar is a real all-rounder. It supports the growth of a broad spectrum of bacteria, yeasts, and molds, making it incredibly useful for a wide range of applications. Whether you’re working with common lab strains or trying to isolate unknown microorganisms from environmental samples, TYCSB Agar often does the trick. Its balanced nutrient profile ensures that even fastidious organisms, which have complex nutritional requirements, can find what they need to flourish. Plus, it’s relatively easy to prepare and cost-effective, which is always a bonus for any lab budget, right? The consistency in its performance across different batches also adds to its appeal. Researchers and technicians can rely on TYCSB Agar to provide reproducible results, which is absolutely critical in scientific work. No one wants to spend precious time troubleshooting media when they could be doing actual science! This reliability saves time, reduces waste, and ensures that your experiments are built on a solid foundation. Furthermore, TYCSB Agar can often be modified or supplemented to enhance its selectivity or differential properties, adding another layer of utility for specific applications. This adaptability means it can be tailored to meet evolving research needs, further cementing its status as a valuable tool in the microbiologist’s toolkit. The fact that it’s widely available from various suppliers also contributes to its easy integration into existing laboratory workflows.
The Science Behind the Success: Key Components of TYCSB Agar
Let’s get down to the nitty-gritty, the actual ingredients that make TYCSB Agar the powerhouse it is. Understanding these components helps us appreciate why it works so well for so many different microbes. It’s not just magic, guys; it’s good science!
Tryptone: The Protein Powerhouse
First up, we have Tryptone . What is it, you ask? Well, it’s a digest of casein, which is a major protein found in milk. It’s broken down into smaller peptides and amino acids through enzymatic or acid hydrolysis. Think of it as pre-digested protein – super easy for microbes to absorb and use for energy and building blocks. These amino acids and short peptides are vital for microbial growth, acting as essential precursors for protein synthesis and other metabolic pathways. Tryptone also provides a good source of nitrogen, which is fundamental for cell structure and function. The specific composition of tryptone can vary slightly depending on the manufacturer and the enzymatic process used, but generally, it offers a rich and readily available source of nutrients that supports the growth of a vast array of bacterial species, including many that might be picky eaters with less complex media. Its consistent quality and nutritional value make it a cornerstone ingredient in many microbiological media, including TYCSB Agar. The peptides in tryptone are particularly beneficial as they require less metabolic effort from the microbe to break down compared to intact proteins, leading to faster and more robust growth. This makes it indispensable for applications where rapid proliferation of microbial cultures is desired, such as in diagnostic testing or inoculum preparation. The richness of tryptone contributes significantly to the overall support of microbial life within the agar medium.
Yeast Extract: The Vitamin and Growth Factor Bonanza
Next, we have Yeast Extract . This is another fantastic source of nutrients, derived from the autolysis (self-digestion) of yeast cells. It’s packed with B vitamins (like thiamine, riboflavin, niacin, and folic acid), amino acids, peptides, carbohydrates, and other growth factors. These components are essential for a microbe’s metabolic processes and overall cell health. Yeast extract is like a multivitamin for your microbes, providing all those little extras they need to really get going and multiply. The complex mixture of compounds in yeast extract ensures that a wide range of metabolic pathways can be supported, promoting vigorous growth even in microorganisms with diverse nutritional needs. B vitamins, in particular, are critical coenzymes in many enzymatic reactions involved in energy production and biosynthesis. The amino acids and peptides supplement those provided by tryptone, offering a broader spectrum of building blocks for protein synthesis. Furthermore, yeast extract contains nucleotides and other signaling molecules that can influence microbial growth and development. Its inherent richness and broad nutritional profile make it a highly valuable component in many microbial culture media, contributing significantly to the success of TYCSB Agar in supporting a diverse range of microorganisms. The synergistic effect of yeast extract with tryptone creates a highly supportive environment for microbial cultivation, ensuring that even fastidious organisms can find the necessary sustenance for optimal growth and activity. Its inclusion is a testament to providing a comprehensive nutritional package for microbial life.
Casein Soya Peptone: The Broad-Spectrum Support
Finally, we have Casein Soya Peptone . This component adds another layer of nutritional complexity and support. Casein peptone is derived from casein (the primary protein in milk), broken down into smaller peptides. Soya peptone, derived from soybeans, provides a good source of nitrogen, amino acids, and carbohydrates. Together, they offer a broad spectrum of nutrients that can support the growth of a wide variety of microorganisms, including bacteria and fungi. This blend enhances the overall nutritive value of the agar, ensuring that even organisms with less common or more complex nutritional requirements can find the sustenance they need. The combination of casein and soya provides a balanced profile of essential nutrients, including a rich source of nitrogen and various amino acids that are crucial for microbial biomass production. Soya peptone, in particular, is known for its excellent growth-promoting properties and can contribute to the formation of larger and more robust colonies. The peptones in this mix are partially hydrolyzed proteins, making them more readily available for microbial uptake than intact proteins. This component is particularly important for organisms that may not efficiently utilize the amino acids and peptides found in tryptone and yeast extract alone. The inclusion of casein soya peptone in TYCSB Agar broadens its applicability, making it suitable for a wider range of microbial species and applications, thus enhancing its reputation as a versatile and dependable growth medium. This component ensures that the agar provides a robust foundation for microbial cultivation, supporting diverse metabolic activities and cellular functions, which is vital for general-purpose culturing.
Agar: The Solid Foundation
And, of course, we can’t forget Agar itself! This is the gelling agent that turns our nutrient broth into a solid or semi-solid medium. Derived from seaweed, agar is a complex carbohydrate that remains solid even at relatively high temperatures and is not typically metabolized by most microorganisms. This means it provides a stable surface for microbial growth, allowing us to isolate colonies, perform streak plating, and observe colony morphology. Without agar, we’d just have a soupy mess, and where’s the fun in that? The unique properties of agar, such as its ability to form a firm gel at low concentrations (usually 1.5-2.0% w/v) and its high melting point (around 85°C) and gelling point (around 32-42°C), make it the ideal solidifying agent for microbiological culture media. This thermal hysteresis is beneficial because it allows the molten agar to be poured into plates or tubes at a temperature low enough not to kill the microbes but high enough to remain liquid during the pouring process. Once solidified, it provides a stable matrix that prevents the diffusion of nutrients and metabolic products, allowing for the isolation and enumeration of microbial populations based on colony formation. The inert nature of agar ensures that it does not interfere with the growth or metabolic activities of the microorganisms, providing a neutral yet supportive environment for cultivation. Its clarity when melted also allows for easy observation of colony characteristics, which is important for identification and characterization purposes. Therefore, agar is the unsung hero that gives structure and form to our microbial habitats.
Applications: Where Does TYCSB Agar Shine?
So, now that we know what goes into TYCSB Agar , let’s talk about where this awesome medium really shines. Its versatility means it pops up in a bunch of different scenarios in the lab. Get ready to see why it’s such a go-to!
General Purpose Cultivation and Isolation
This is probably the most common use, guys. TYCSB Agar is fantastic for the general cultivation of a wide variety of non-fastidious microorganisms. If you just need to grow up a bacterial culture, check for microbial contamination, or isolate bacteria from a sample (like soil, water, or food), TYCSB Agar is often your first port of call. It provides a rich, supportive environment that allows most common bacteria to grow well, forming visible colonies that you can then pick and subculture for further study. Its broad nutritional base means you don’t have to worry too much about whether your target organism has specific dietary needs; chances are, TYCSB Agar has got it covered. This makes it ideal for introductory microbiology courses where students are learning basic techniques like plating and colony identification. For environmental microbiology, TYCSB Agar serves as an excellent general medium for assessing microbial diversity in various samples. Its ability to support a wide range of bacterial and fungal species allows researchers to obtain a broad overview of the microbial communities present. Similarly, in food safety testing, it can be used as a general screening medium to detect the presence of viable microorganisms that could indicate spoilage or potential health risks. The straightforward preparation and reliable performance make it an efficient tool for routine microbiological analysis across different industries, from agriculture to pharmaceuticals, ensuring the quality and safety of products and processes. Its ability to support the growth of both aerobes and facultative anaerobes further enhances its utility in diverse sample types.
Quality Control in Various Industries
In industries like food and beverage, pharmaceuticals, and cosmetics, TYCSB Agar plays a crucial role in quality control. It’s used to test raw materials, in-process samples, and finished products for microbial contamination. Ensuring that products are free from harmful bacteria or spoilage organisms is paramount, and TYCSB Agar provides a reliable method for detecting their presence. Regular testing using a robust medium like TYCSB Agar helps companies maintain product integrity, comply with regulatory standards, and protect consumer health. Think about it: you wouldn’t want your favorite yogurt or medicine to be full of unwanted microbes, right? TYCSB Agar helps prevent that. Its sensitivity allows for the detection of low levels of contamination, providing an early warning system for potential issues in the manufacturing process. Pharmaceutical companies rely on it to test the sterility of their products and the microbial load in their manufacturing environments, adhering to stringent Good Manufacturing Practices (GMP). In the food industry, it’s used to monitor hygiene levels and identify potential sources of contamination throughout the production chain, from farm to fork. This consistent use in QC applications underscores its importance in ensuring public health and safety across multiple sectors. The ability to use it for both qualitative (presence/absence) and quantitative (counting colonies) assessments adds to its value in comprehensive quality assurance programs.
Stock Cultures and Maintenance
Need to keep a microbial strain viable for future experiments? TYCSB Agar is a solid choice for maintaining stock cultures. You can grow up your desired organism on TYCSB Agar, and then store the plates under appropriate conditions (like refrigeration). This ensures you have a reliable source of healthy, viable cells ready whenever you need them. Keeping good stock cultures is fundamental to reproducible research, and TYCSB Agar makes this process straightforward. By providing a nutrient-rich environment, it supports the long-term viability of microbial strains without encouraging excessive growth that could lead to genetic drift or depletion of essential nutrients. Subculturing onto fresh TYCSB Agar periodically helps to maintain the vigor and genetic stability of the cultures. For researchers working with microbial collections or culture repositories, TYCSB Agar offers a dependable and economical medium for preserving a diverse range of microorganisms. Its formulation is designed to support sustained growth, making it easier to revive cultures after prolonged storage. This ease of maintenance reduces the risk of losing valuable microbial strains due to poor viability or contamination, thereby safeguarding ongoing research projects and ensuring the continuity of scientific investigations. The robust nature of the growth supported by TYCSB Agar also means that even less vigorous strains can often be successfully maintained, broadening its applicability in culture collection management.
Educational Purposes
In academic settings, TYCSB Agar is a fantastic teaching tool. It’s used in undergraduate and graduate microbiology labs to teach fundamental techniques like aseptic technique, streak plating, pour plating, and colony counting. Because it supports the growth of a wide range of common, non-pathogenic bacteria, it’s safe and effective for students to use. Learning microbiology on a reliable medium like TYCSB Agar builds a strong foundation for future scientific endeavors. Students can observe different colony morphologies, practice microbial identification techniques, and understand the principles of microbial growth in a tangible way. The ease with which students can achieve successful growth on TYCSB Agar boosts confidence and engagement in learning. It allows educators to focus on teaching core microbiological concepts and techniques without the added complication of finicky media formulations. The visual results obtained on TYCSB Agar – clear colonies on a solid background – are highly effective for demonstrating microbial growth and the principles of culturing. This makes it an indispensable component of practical microbiology education, helping to inspire the next generation of scientists. Its cost-effectiveness also makes it accessible for large student groups, ensuring that practical learning opportunities are widely available. The medium’s consistency across different batches further contributes to a predictable learning experience for students, minimizing variability that could otherwise distract from the educational objectives.
Tips for Using TYCSB Agar Like a Pro
Alright, you’ve got your TYCSB Agar , you know what it’s for, now let’s talk about getting the best results. Here are a few tips to elevate your game, guys:
Proper Preparation is Key
Always follow the manufacturer’s instructions for rehydrating and sterilizing the TYCSB Agar powder. Use distilled or deionized water, ensure all powder is dissolved before autoclaving, and sterilize appropriately (usually 15 psi for 15 minutes). Over- or under-autoclaving can affect the gelling properties and nutrient availability. If you’re preparing it yourself from raw ingredients, ensure accurate weighing and thorough mixing. Proper sterilization is critical to prevent contamination of your medium, which would otherwise lead to unreliable results. For poured plates, allow the molten agar to cool to around 45-50°C before pouring into sterile Petri dishes to avoid damaging the agar or creating excessive condensation. Swirl gently to mix, but avoid introducing bubbles. Once poured, let the plates solidify completely on a level surface before inverting them. Inverting the plates prevents condensation from dripping onto the agar surface, which can cause colonies to spread and merge, making isolation and counting difficult. Proper preparation ensures that the medium is sterile, has the correct physical consistency, and provides optimal nutrient availability for microbial growth, setting the stage for successful experiments.
Storage Matters
Store TYCSB Agar powder in a cool, dry place, tightly sealed to prevent moisture absorption. Prepared, autoclaved, and cooled agar plates should be stored inverted (upside down) in sterile bags or containers, typically in the refrigerator (2-8°C). Check for contamination or signs of dehydration before use. Refrigeration slows down the degradation of nutrients and prevents microbial spoilage, extending the shelf life of your prepared media. When retrieving plates from storage, allow them to come to room temperature before inoculating. This prevents condensation from forming on the surface when they are exposed to warmer incubator temperatures, which can interfere with colony growth and morphology. Properly stored media ensure consistent performance and reduce waste, contributing to the efficiency and reliability of your microbiological work. Using older or improperly stored media can lead to inconsistent growth, slower incubation times, or even the failure of your experiments, so paying attention to storage conditions is a small step that yields significant benefits in terms of accuracy and reproducibility. The goal is always to have fresh, reliable media ready for use, and proper storage is the pathway to achieving that.
Know Your Organisms
While TYCSB Agar is versatile, remember that extremely fastidious organisms (those with very specific and complex nutritional needs) might require supplemented media. If you’re consistently getting poor or no growth, consider if your target organism might need specific growth factors, vitamins, or amino acids that aren’t abundantly present in the base TYCSB formulation. You might need to add supplements like blood, serum, or specific enrichment factors. Always consult relevant literature for the optimal growth requirements of your specific microorganism. Understanding the basic nutritional needs of the organisms you work with is key to successful cultivation. For instance, some anaerobic bacteria or specific pathogenic species may require enriched media or selective agents in addition to a general nutrient base. TYCSB Agar is an excellent starting point, but knowing when to modify it is part of being a skilled microbiologist. This knowledge allows you to troubleshoot effectively and choose the most appropriate medium for your specific research question, ultimately saving time and resources while improving the quality of your results. By having a foundational understanding of microbial physiology, you can make informed decisions about media selection and supplementation, leading to more efficient and successful cultivation efforts.
Incubation Conditions
Don’t forget that incubation temperature, atmosphere, and time are crucial! TYCSB Agar will support growth over a range of temperatures, but you should incubate your plates at the optimal temperature for the specific microorganism you are cultivating (e.g., 37°C for many common bacteria, or lower for environmental organisms). Ensure the incubator is calibrated and maintaining the correct temperature. Also, consider whether your organism requires aerobic, anaerobic, or microaerophilic conditions. Proper incubation ensures that your microbes grow efficiently and that you can obtain reliable results within a reasonable timeframe. Over-incubation can lead to overgrowth, nutrient depletion, and changes in colony morphology, while under-incubation may result in insufficient growth for analysis. Always refer to established protocols or literature for the recommended incubation parameters for your specific organism or application. This attention to detail in the incubation phase is just as important as the media used, ensuring that all variables are optimized for successful microbial cultivation and accurate experimental outcomes. It’s the final step in creating the perfect environment for your microbes to show you what they can do.
Conclusion: TYCSB Agar - A Reliable Workhorse
So there you have it, guys! TYCSB Agar is more than just a name on a bottle; it’s a reliable, versatile, and essential tool in any microbiology lab. Its balanced nutrient profile, derived from carefully selected components like tryptone, yeast extract, and casein soya peptone, provides a supportive environment for a vast array of microorganisms. From basic research and education to stringent quality control in various industries, TYCSB Agar consistently delivers. By understanding its composition and following best practices for preparation, storage, and use, you can ensure you’re getting the most out of this fantastic medium. It truly is a workhorse that simplifies many microbiological tasks, allowing us to focus on the exciting science behind microbial life. Keep experimenting, keep learning, and keep those cultures growing!